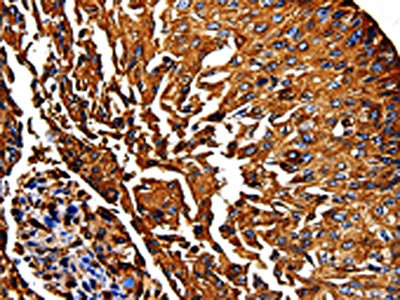

PKM Antibody
-
中文名稱:PKM兔多克隆抗體
-
貨號:CSB-PA057752
-
規(guī)格:¥1100
-
圖片:
-
The image on the left is immunohistochemistry of paraffin-embedded Human lung cancer tissue using CSB-PA057752(PKM Antibody) at dilution 1/50, on the right is treated with fusion protein. (Original magnification: ×200)
-
Gel: 8%SDS-PAGE, Lysate: 30 μg, Lane: Hela cells, Primary antibody: CSB-PA057752(PKM Antibody) at dilution 1/500, Secondary antibody: Goat anti rabbit IgG at 1/8000 dilution, Exposure time: 5 seconds
-
-
其他:
產(chǎn)品詳情
-
Uniprot No.:
-
基因名:
-
別名:CTHBP antibody; Cytosolic thyroid hormone-binding protein antibody; KPYM_HUMAN antibody; OIP-3 antibody; Opa-interacting protein 3 antibody; p58 antibody; pkm antibody; PKM1 antibody; PKM2 antibody; Pyruvate kinase 2/3 antibody; Pyruvate kinase muscle isozyme antibody; Pyruvate kinase PKM antibody; THBP1 antibody; Thyroid hormone-binding protein 1 antibody; Tumor M2-PK antibody
-
宿主:Rabbit
-
反應(yīng)種屬:Human,Mouse,Rat
-
免疫原:Fusion protein of Human PKM
-
免疫原種屬:Homo sapiens (Human)
-
標(biāo)記方式:Non-conjugated
-
抗體亞型:IgG
-
純化方式:Antigen affinity purification
-
濃度:It differs from different batches. Please contact us to confirm it.
-
保存緩沖液:-20°C, pH7.4 PBS, 0.05% NaN3, 40% Glycerol
-
產(chǎn)品提供形式:Liquid
-
應(yīng)用范圍:ELISA,WB,IHC
-
推薦稀釋比:
Application Recommended Dilution ELISA 1:500-1:5000 WB 1:500-1:2000 IHC 1:50-1:200 -
Protocols:
-
儲存條件:Upon receipt, store at -20°C or -80°C. Avoid repeated freeze.
-
貨期:Basically, we can dispatch the products out in 1-3 working days after receiving your orders. Delivery time maybe differs from different purchasing way or location, please kindly consult your local distributors for specific delivery time.
-
用途:For Research Use Only. Not for use in diagnostic or therapeutic procedures.
相關(guān)產(chǎn)品
靶點詳情
-
功能:Glycolytic enzyme that catalyzes the transfer of a phosphoryl group from phosphoenolpyruvate (PEP) to ADP, generating ATP. The ratio between the highly active tetrameric form and nearly inactive dimeric form determines whether glucose carbons are channeled to biosynthetic processes or used for glycolytic ATP production. The transition between the 2 forms contributes to the control of glycolysis and is important for tumor cell proliferation and survival. In addition to its role in glycolysis, also regulates transcription. Stimulates POU5F1-mediated transcriptional activation. Promotes in a STAT1-dependent manner, the expression of the immune checkpoint protein CD274 in ARNTL/BMAL1-deficient macrophages. Also acts as a translation regulator for a subset of mRNAs, independently of its pyruvate kinase activity: associates with subpools of endoplasmic reticulum-associated ribosomes, binds directly to the mRNAs translated at the endoplasmic reticulum and promotes translation of these endoplasmic reticulum-destined mRNAs. Plays a general role in caspase independent cell death of tumor cells.
-
基因功能參考文獻(xiàn):
- results reveal that nBP1a/PKM2 interaction activates lipid metabolism genes in cancer cells and that Thr-59 phosphorylation of SREBP-1a plays an important role in cancer cell proliferation. PMID: 29514980
- we demonstrated that knockdown of PKM2 can inhibit GC cell proliferation, G1-S phase transition, can, especially, attenuate GC cell migration in vivo and in vitro, per contra, promote the autophagy, which may depend on mediating the PI3K-Akt signaling. PMID: 28588255
- PKM1 activated glucose catabolism and stimulated autophagy/mitophagy, favoring malignancy PMID: 29533781
- miRNA-139-5p inhibited cell proliferation, migration, and glycolysis in GBC, at least in part, by repressing pyruvate kinase M2 PMID: 30105813
- Mammalian target of rapamycin pathway promotes aerobic glycolysis in esophageal squamous cell carcinoma by upregulating pyruvate kinase M2 isoform PMID: 29916308
- PKM2 promotes tumor cell exosome release via phosphorylating protein SNAP23. PMID: 28067230
- proteins such as MMP2 and MMP9 as well as P38 expression were also affected by the PKM2 expression changes. These results proved that PKM2 could be involved in the progression of bladder cancer by mitogen-activated protein kinases signaling pathway. PMID: 30249877
- hypoxic stress in the hepatocellular carcinoma (HCC)cells promoted YAP binding to HIF-1a in the nucleus and sustained HIF-1a protein stability to bind to PKM2 gene and directly activates PKM2 transcription to accelerate glycolysis PMID: 30180863
- overexpressed PKM2 led to increased CCND1 and decreased CDKN1A expression, whereas underexpressed PKM2 led to decreased CCND1 and increased CDKN1A expression in ovarian cancer cells. PMID: 29752805
- Our current study thus unveils a distinct regulatory function of PKM2, providing new options for therapeutic intervention targeting HIV-1-host interactions. PMID: 29607934
- PKM2 as a novel target of RUNX1-ETO and is specifically downregulated in RUNX1-ETO positive AML patients, indicating that PKM2 level might have a diagnostic potential in RUNX1-ETO associated AML. PMID: 28092997
- High M2-PK expression is associated with pancreatic cancer and peri-ampullary cancer. PMID: 29540198
- The activity of PKM2 was indispensable for the development and metastasis of OS. PMID: 29155364
- fFndings demonstrate that mDC activation requires an elevated intrinsic PKM2 level and that PKM2 improves the immune status of patients with SAA by enhancing the functions of mDCs and, consequently, CTLs. PMID: 29636835
- EGFR activation results in c-Src-mediated Cdc25A phosphorylation at Y59, which interacts with nuclear pyruvate kinase M2 (PKM2). PMID: 27485204
- Study demonstrate that PKM2 plays an important role in metabolic activities, as well as in the malignancy of pancreatic ductal adenocarcinoma cells. PMID: 29393401
- Suggest a critical role for pyruvate kinase isozyme M2 in mediating the interaction between pancreatic cancer cells and pancreatic stellate cells. PMID: 29619774
- Results show that PK2 expression level is regulated by HSP90 in hepatocellular carcinoma (HCC). HSP90 enhances PKM2 stability by inducing the phosphorylation of PKM2 at Thr-328. PMID: 29262861
- O-GlcNAcylation is a regulatory mechanism for PKM2 in cancer cells and serves as a bridge between PKM2 and metabolic reprogramming typical of the Warburg effect. PMID: 29229835
- Results indicate that PKM2 is positively correlated with Sp1 expression and demonstrate that Sp1 directly regulates its expression in castration-resistant prostate cancer. PMID: 29094170
- High PKM2 expression is associated with lung adenocarcinoma. PMID: 28489603
- Epigenetic silencing of miR-338 facilitates glioblastoma progression by preventing suppression the PKM2/beta-catenin axis. PMID: 28858851
- this study correlates TuM2PK with tumor size, CRP and CA 15-3 in metastatic breast carcinomas. PMID: 28869444
- PKM2 modulates the glycolysis and extracellular matrix generation, providing the vital role of PKM2 on osteoarthritis (OA) pathogenesis and a novel therapeutic target for OA. PMID: 29356574
- This work suggested that OA increased PKM1/PKM2 ratio, resulting in HNF-4alpha activation and hepatoma differentiation. PMID: 28726775
- the present findings enriched our knowledge by demonstrating a significant association of PKM2 and GLS1 with oxaliplatin-resistance in CRC. PMID: 28498807
- Elevated expression of PKM2 is a prognostic factor for poor gallbladder cancer (GBC) clinical outcomes, implied involving of PKM2 in GBC progression. PMID: 27283076
- PKM2 knockdown resulted in increased p53 expression and prolonged half-life of p53. PKM2 could directly bind with both p53 and MDM2 and promote MDM2-mediated p53 ubiquitination. The dimeric PKM2 significantly suppressed p53 expression compared with the other PKM2 mutants. PMID: 27801666
- Inhibition of the mTOR pathway abolished TGF-beta1-induced EMT and reduced mTOR/p70s6k signaling, which downregulated PKM2 expression. PMID: 28446743
- Study indicates that nitric oxide induces PKM2 nuclear translocation and promotes glycolysis in ovarian cancer cells. PMID: 28380434
- Authors report that AKT directly interacts with PKM2 and phosphorylates it at Ser-202, which is essential for the nuclear translocation of PKM2 protein under stimulation of IGF-1. In the nucleus, PKM2 binds to STAT5A and induces IGF-1-stimulated cyclin D1 expression, suggesting that PKM2 acts as an important factor inducing STAT5A activation under IGF-1 signaling. PMID: 27340866
- The results suggested that targeting PKM2 with an oncolytic adenovirus produced a strong antitumor effect. PMID: 28569774
- our results demonstrated that miR-let-7a inhibits cell proliferation, migration and invasion by down-regulation of PKM2 in cervical cancer PMID: 28415668
- Data show that cytomegalovirus encoded chemokine receptor US28 (US28) signaling in activation of the HIF-1alpha/PKM2 feedforward loop in fibroblasts and glioblastoma cells. PMID: 27602585
- High PKM2 expression is associated urothelial tumorigenesis. PMID: 26992222
- Report that PKM2 is succinylated at lysine 498 and succinylation increases its activity. SIRT5 binds to, desuccinylates and inhibits PKM2 activity. Increased levels of reactive oxygen species (ROS) decreases succinylation and activity of PKM2 by increasing its binding to SIRT5. PMID: 28036303
- over-expression of PKM2 is associated with poor prognosis in most solid cancers and it might be a potentially useful biomarker for predicting cancer prognosis in future clinical applications. PMID: 27911861
- Interdependence of GLO I and PKM2 in the Metabolic shift to escape apoptosis in GLO I-dependent cancer cells PMID: 29225125
- This study demonstrates that lapachol inhibits glycolysis in cancer cells by targeting PKM2. Unlike the previously reported inhibitor shikonin, lapachol does not target mitochondria in tumor cell growth inhibition. PMID: 29394289
- In this study, we indicate that P53 (N340Q/L344R) promotes hepatocarcinogenesis through upregulation of PKM2 PMID: 27167190
- These findings indicate that shRNA-mediated silencing of PKM2 gene promotes apoptosis and inhibits aerobic glycolysis, proliferation, migration, and invasion in colorectal cancer cells. PMID: 28543190
- Due to achieved results concerning expression of PKM2 there is a lack of evidence for its diagnostic and prognostic usage in ovarian cancer. PMID: 29277786
- UCP2 stimulates hnRNPA2/B1, GLUT1 and PKM2 expression and sensitizes pancreatic cancer cells to glycolysis inhibition. PMID: 27989750
- These findings uncover a novel mechanism through which mitochondrial PKM2 phosphorylates Bcl2 and inhibits apoptosis directly. PMID: 28035139
- These findings suggested that PKM2 and GLS might play important roles in the proliferation of hypoxic gastric cancer cells PMID: 29032577
- demonstrated that lincRNA-p21 blunted the prostate cancer cell proliferation and tumorigenic capacity through down-regulation of PKM2 PMID: 28994148
- we demonstrated that SHP-1 dephosphorylates PKM2Y105 to inhibit the Warburg effect and nucleus-dependent cell proliferation, and the dephosphorylation of PKM2Y105 by SHP-1 determines the efficacy of targeted drugs for hepatocellular carcinoma treatment PMID: 26959741
- The PKM2-shRNA group exhibited reduced PKM2 mRNA and protein expression, whereas p53 and p21 expression was increased compared with the blank and empty plasmid groups. PMID: 28746922
- The CARM1-PKM2 axis serves as a metabolic reprogramming mechanism in tumorigenesis. PMID: 29058718
- PKM2 activity is higher in patients with NSCLC than in healthy subjects. The level of PKM2 activity is associated with advanced stage of cancer. PMID: 27683215
顯示更多
收起更多
-
亞細(xì)胞定位:Cytoplasm. Nucleus.
-
蛋白家族:Pyruvate kinase family
-
組織特異性:Specifically expressed in proliferating cells, such as embryonic stem cells, embryonic carcinoma cells, as well as cancer cells.
-
數(shù)據(jù)庫鏈接:
Most popular with customers
-
-
YWHAB Recombinant Monoclonal Antibody
Applications: ELISA, WB, IHC, IF, FC
Species Reactivity: Human, Mouse, Rat
-
-
-
-
-
-